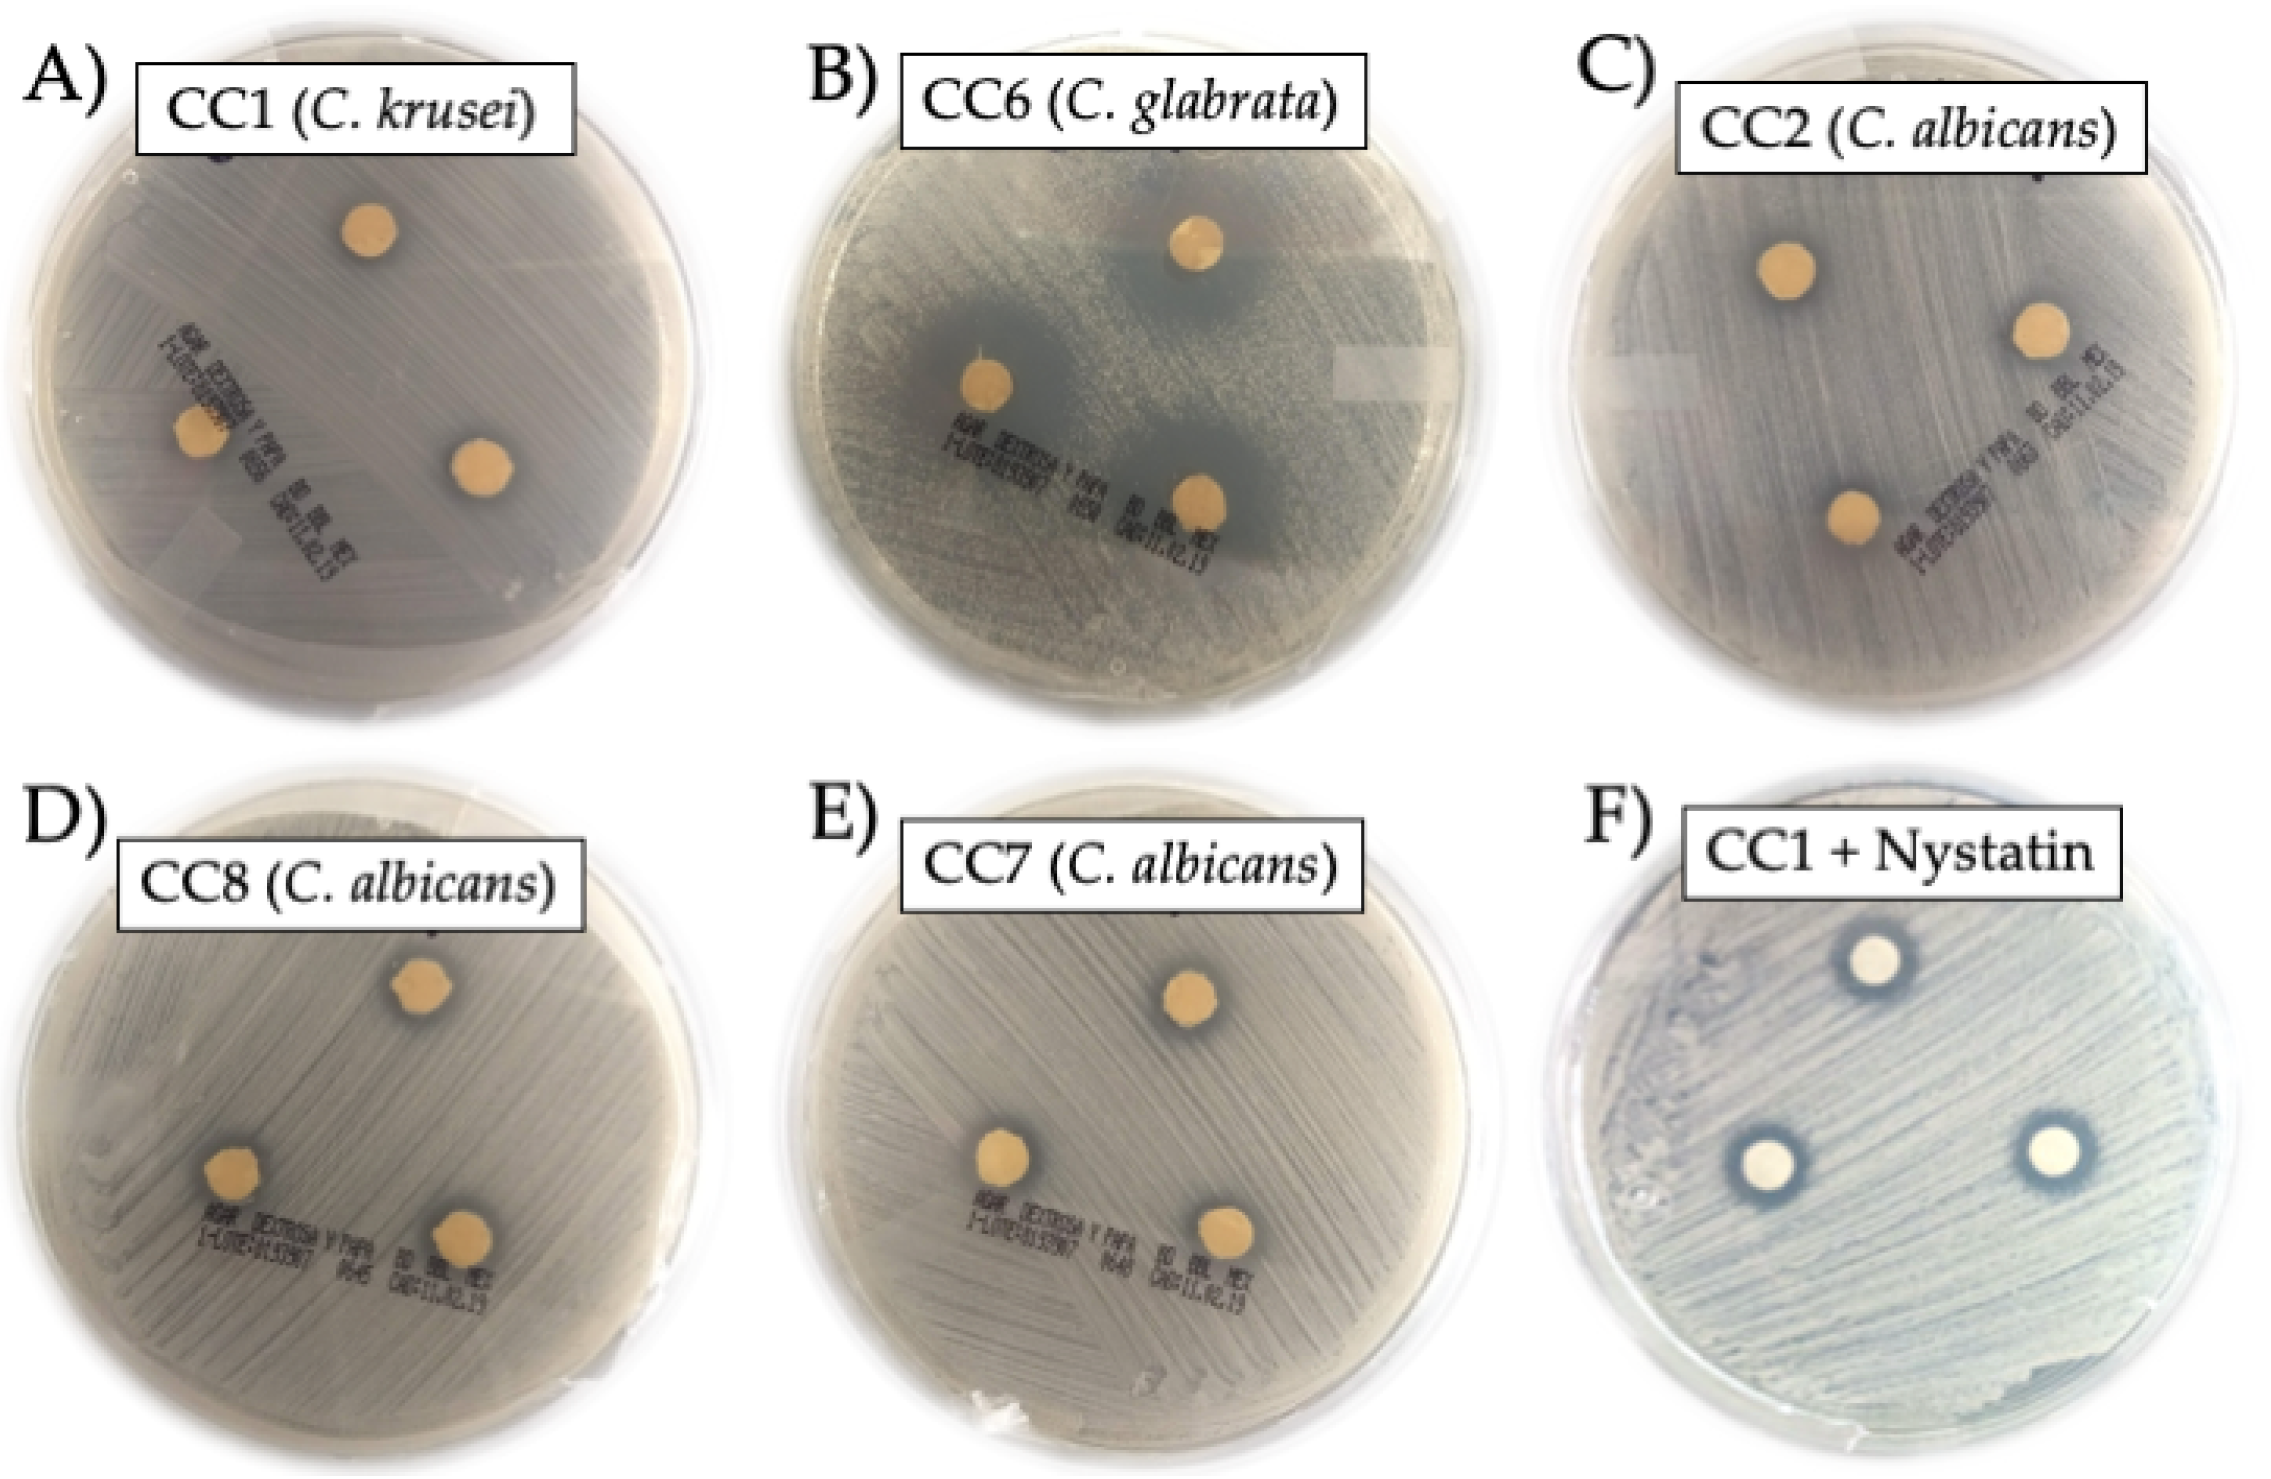
Molecules 27 05651 g002 Molecules 27 05651 g002

Antifungal Activity of Mexican Propolis on Clinical Isolates of Candida Species
Abstract
1. Introduction
2. Results
2.1. Identification of Clinical Isolates of Candida
2.2. Evaluation of the Antifungal Activity of Propolis in Candida
2.3. Evaluation of Candida Germ Tube Growth Inhibition
2.4. Chemical Composition of Mexican Propolis
3. Discussion
4. Materials and Methods
4.1. Obtaining and Preparing Propolis
4.2. Collection of Clinical Samples of Candida
4.3. Candida Species Identification
4.4. Anti-Candida Activity Qualitative and Quantitative Assays
4.5. Candida Germ Tube Growth Inhibition Assay
4.6. General Experimental Procedures and Equipment Utilized for the Determination of the Chemical Composition of Mexican Propolis
Fractionation and Identification of Chemical Constituents from Propolis Methanolic Extract
4.7. Statistical Analysis
5. Conclusions
Supplementary Materials
Author Contributions
Funding
Institutional Review Board Statement
Informed Consent Statement
Data Availability Statement
Conflicts of Interest
References
- An, S.-H.; Ban, E.; Chung, I.-Y.; Cho, Y.-H.; Kim, A. Antimicrobial Activities of Propolis in Poloxamer Based Topical Gels. Pharmaceutics 2021, 13, 2021. [Google Scholar] [CrossRef]
- Meto, A.; Colombari, B.; Meto, A.; Boaretto, G.; Pinetti, D.; Marchetti, L.; Benvenuti, S.; Pellati, F.; Blasi, E. Propolis affects Pseudomonas aeruginosa growth, biofilm formation, eDNA release and phenazine production: Potential involvement of polyphenols. Microorganisms 2020, 8, 243. [Google Scholar] [CrossRef] [PubMed]
- Przybyłek, I.; Karpiński, T.M. Antibacterial properties of propolis. Molecules 2019, 24, 2047. [Google Scholar] [CrossRef] [PubMed]
- Cerqueira, P.; Cunha, A.; Almeida-Aguiar, C. Potential of propolis antifungal activity for clinical applications. J. Appl. Microbiol. 2022. [Google Scholar] [CrossRef] [PubMed]
- Fernández-Calderón, M.C.; Hernández-González, L.; Gómez-Navia, C.; Blanco-Blanco, M.T.; Sánchez-Silos, R.; Lucio, L.; Pérez-Giraldo, C. Antifungal and anti-biofilm activity of a new Spanish extract of propolis against Candida glabrata. BMC Complementary Med. Ther. 2021, 21, 147. [Google Scholar] [CrossRef]
- Magnavacca, A.; Sangiovanni, E.; Racagni, G.; Dell’Agli, M. The antiviral and immunomodulatory activities of propolis: An update and future perspectives for respiratory diseases. Med. Res. Rev. 2022, 42, 897–945. [Google Scholar] [CrossRef]
- Shimizu, T.; Hino, A.; Tsutsumi, A.; Park, Y.K.; Watanabe, W.; Kurokawa, M. Anti-influenza virus activity of propolis in vitro and its efficacy against influenza infection in mice. Antiviral Chem. Chemother. 2008, 19, 7–13. [Google Scholar] [CrossRef]
- Zulhendri, F.; Chandrasekaran, K.; Kowacz, M.; Ravalia, M.; Kripal, K.; Fearnley, J.; Perera, C.O. Antiviral, antibacterial, antifungal, and antiparasitic properties of propolis: A Review. Foods 2021, 10, 1360. [Google Scholar] [CrossRef]
- De L. Paula, L.A.; Candido, A.C.; Santos, M.F.; Caffrey, C.R.; Bastos, J.K.; Ambrosio, S.R.; Magalhaes, L.G. Antiparasitic properties of propolis extracts and their compounds. Chem. Biodivers. 2021, 18, e2100310. [Google Scholar]
- Zaccaria, V.; Curti, V.; Di Lorenzo, A.; Baldi, A.; Maccario, C.; Sommatis, S.; Mocchi, R.; Daglia, M. Effect of green and brown propolis extracts on the expression levels of microRNAs, mRNAs and proteins, related to oxidative stress and inflammation. Nutrients 2017, 9, 1090. [Google Scholar] [CrossRef]
- El-Seedi, H.R.; Eid, N.; Abd El-Wahed, A.A.; Rateb, M.E.; Afifi, H.S.; Algethami, A.F.; Zhao, C.; Al Naggar, Y.; Alsharif, S.M.; Tahir, H.E. Honey Bee Products: Preclinical and Clinical Studies of Their Anti-inflammatory and Immunomodulatory Properties. Front. Nutr. 2022, 8, 761267. [Google Scholar] [CrossRef]
- Forma, E.; Bryś, M. Anticancer activity of propolis and its compounds. Nutrients 2021, 13, 2594. [Google Scholar] [CrossRef]
- Elumalai, P.; Muninathan, N.; Megalatha, S.T.; Suresh, A.; Kumar, K.S.; Jhansi, N.; Kalaivani, K.; Krishnamoorthy, G. An Insight into Anticancer Effect of Propolis and Its Constituents: A Review of Molecular Mechanisms. Evid.-Based Complementary Altern. Med. 2022, 2022, 14. [Google Scholar] [CrossRef]
- Rivera-Yañez, N.; Rivera-Yañez, C.R.; Pozo-Molina, G.; Méndez-Catalá, C.F.; Méndez-Cruz, A.R.; Nieto-Yañez, O. Biomedical properties of propolis on diverse chronic diseases and its potential applications and health benefits. Nutrients 2020, 13, 78. [Google Scholar] [CrossRef]
- Kitamura, H. Effects of propolis extract and propolis-derived compounds on obesity and diabetes: Knowledge from cellular and animal models. Molecules 2019, 24, 4394. [Google Scholar] [CrossRef]
- Al-Hariri, M. Immune’s-boosting agent: Immunomodulation potentials of propolis. J. Fam. Community Med. 2019, 26, 57. [Google Scholar] [CrossRef]
- Búfalo, M.C.; Bordon-Graciani, A.P.; Conti, B.J.; de Assis Golim, M.; Sforcin, J.M. The immunomodulatory effect of propolis on receptors expression, cytokine production and fungicidal activity of human monocytes. J. Pharm. Pharmacol. 2014, 66, 1497–1504. [Google Scholar] [CrossRef]
- Oladayo, M.I. Nigerian propolis improves blood glucose, glycated hemoglobin A1c, very low-density lipoprotein, and high-density lipoprotein levels in rat models of diabetes. J. Intercult. Ethnopharmacol. 2016, 5, 233. [Google Scholar]
- Zakerkish, M.; Jenabi, M.; Zaeemzadeh, N.; Hemmati, A.A.; Neisi, N. The effect of Iranian propolis on glucose metabolism, lipid profile, insulin resistance, renal function and inflammatory biomarkers in patients with type 2 diabetes mellitus: A randomized double-blind clinical trial. Sci. Rep. 2019, 9, 7289. [Google Scholar] [CrossRef]
- Afsharpour, F.; Javadi, M.; Hashemipour, S.; Koushan, Y. Propolis supplementation improves glycemic and antioxidant status in patients with type 2 diabetes: A randomized, double-blind, placebo-controlled study. Complement. Ther. Med. 2019, 43, 283–288. [Google Scholar] [CrossRef]
- Bankova, V. Recent trends and important developments in propolis research. Evid.-Based Complement. Altern. Med. 2005, 2, 29–32. [Google Scholar] [CrossRef] [PubMed]
- Romo, J.A.; Kumamoto, C.A. On commensalism of Candida. J. Fungi 2020, 6, 16. [Google Scholar] [CrossRef]
- Kumamoto, C.A.; Gresnigt, M.S.; Hube, B. The gut, the bad and the harmless: Candida albicans as a commensal and opportunistic pathogen in the intestine. Curr. Opin. Microbiol. 2020, 56, 7–15. [Google Scholar] [CrossRef]
- Bacali, C.; Vulturar, R.; Buduru, S.; Cozma, A.; Fodor, A.; Chiș, A.; Lucaciu, O.; Damian, L.; Moldovan, M.L. Oral Microbiome: Getting to Know and Befriend Neighbors, a Biological Approach. Biomedicines 2022, 10, 671. [Google Scholar] [CrossRef]
- Hameed, S.; Hans, S.; Monasky, R.; Thangamani, S.; Fatima, Z. Understanding human microbiota offers novel and promising therapeutic options against Candida infections. Pathogens 2021, 10, 183. [Google Scholar] [CrossRef]
- Boxberger, M.; Cenizo, V.; Cassir, N.; La Scola, B. Challenges in exploring and manipulating the human skin microbiome. Microbiome 2021, 9, 125. [Google Scholar] [CrossRef]
- Tortelli, B.A.; Lewis, W.G.; Allsworth, J.E.; Member-Meneh, N.; Foster, L.R.; Reno, H.E.; Peipert, J.F.; Fay, J.C.; Lewis, A.L. Associations between the vaginal microbiome and Candida colonization in women of reproductive age. Am. J. Obstet. Gynecol. 2020, 222, 471.e1–471.e9. [Google Scholar] [CrossRef] [PubMed]
- Chee, W.J.Y.; Chew, S.Y.; Than, L.T.L. Vaginal microbiota and the potential of Lactobacillus derivatives in maintaining vaginal health. Microb. Cell Factories 2020, 19, 1–24. [Google Scholar] [CrossRef]
- Kalia, N.; Singh, J.; Kaur, M. Microbiota in vaginal health and pathogenesis of recurrent vulvovaginal infections: A critical review. Ann. Clin. Microbiol. Antimicrob. 2020, 19, 5. [Google Scholar] [CrossRef] [PubMed]
- Perez, J.C. Fungi of the human gut microbiota: Roles and significance. Int. J. Med. Microbiol. 2021, 311, 151490. [Google Scholar] [CrossRef] [PubMed]
- Horn, D.L.; Neofytos, D.; Anaissie, E.J.; Fishman, J.A.; Steinbach, W.J.; Olyaei, A.J.; Marr, K.A.; Pfaller, M.A.; Chang, C.-H.; Webster, K.M. Epidemiology and outcomes of candidemia in 2019 patients: Data from the prospective antifungal therapy alliance registry. Clin. Infect. Dis. 2009, 48, 1695–1703. [Google Scholar] [CrossRef] [PubMed]
- Miceli, M.H.; Díaz, J.A.; Lee, S.A. Emerging opportunistic yeast infections. Lancet Infect. Dis. 2011, 11, 142–151. [Google Scholar] [CrossRef]
- Bongomin, F.; Gago, S.; Oladele, R.O.; Denning, D.W. Global and multi-national prevalence of fungal diseases—Estimate precision. J. Fungi 2017, 3, 57. [Google Scholar] [CrossRef] [PubMed]
- Mareković, I.; Pleško, S.; Rezo Vranješ, V.; Herljević, Z.; Kuliš, T.; Jandrlić, M. Epidemiology of candidemia: Three-year results from a croatian tertiary care hospital. J. Fungi 2021, 7, 267. [Google Scholar] [CrossRef]
- D’Auria, F.D.; Casciaro, B.; De Angelis, M.; Marcocci, M.E.; Palamara, A.T.; Nencioni, L.; Mangoni, M.L. Antifungal Activity of the Frog Skin Peptide Temporin G and Its Effect on Candida albicans Virulence Factors. Int. J. Mol. Sci. 2022, 23, 6345. [Google Scholar] [CrossRef] [PubMed]
- Mayer, F.L.; Wilson, D.; Hube, B. Candida albicans pathogenicity mechanisms. Virulence 2013, 4, 119–128. [Google Scholar] [CrossRef] [PubMed]
- Tsui, C.; Kong, E.F.; Jabra-Rizk, M.A. Pathogenesis of Candida albicans biofilm. Pathog. Dis. 2016, 74, fte018. [Google Scholar] [CrossRef]
- Cavalheiro, M.; Teixeira, M.C. Candida biofilms: Threats, challenges, and promising strategies. Front. Med. 2018, 5, 28. [Google Scholar] [CrossRef]
- Shaikh, M.S.; Alnazzawi, A.; Habib, S.R.; Lone, M.A.; Zafar, M.S. Therapeutic role of nystatin added to tissue conditioners for treating denture-induced stomatitis: A systematic review. Prosthesis 2021, 3, 61–74. [Google Scholar] [CrossRef]
- Zager, R.A. Polyene antibiotics: Relative degrees of in vitro cytotoxicity and potential effects on tubule phospholipid and ceramide content. Am. J. Kidney Dis. 2000, 36, 238–249. [Google Scholar] [CrossRef]
- Barantsevich, N.; Barantsevich, E. Diagnosis and Treatment of Invasive Candidiasis. Antibiotics 2022, 11, 718. [Google Scholar] [CrossRef]
- Anderson, T.M.; Clay, M.C.; Cioffi, A.G.; Diaz, K.A.; Hisao, G.S.; Tuttle, M.D.; Nieuwkoop, A.J.; Comellas, G.; Maryum, N.; Wang, S. Amphotericin forms an extramembranous and fungicidal sterol sponge. Nat. Chem. Bio. 2014, 10, 400–406. [Google Scholar] [CrossRef]
- Robbins, N.; Caplan, T.; Cowen, L.E. Molecular evolution of antifungal drug resistance. Ann. Rev. Microbiol 2017, 71, 753–775. [Google Scholar] [CrossRef]
- Gintjee, T.J.; Donnelley, M.A.; Thompson III, G.R. Aspiring antifungals: Review of current antifungal pipeline developments. J. Fungi 2020, 6, 28. [Google Scholar] [CrossRef]
- Jha, A.; Vimal, A.; Kumar, A. Target shortage and less explored multiple targeting: Hurdles in the development of novel antifungals but overcome/addressed effectively through structural bioinformatics. Brief. Bioinf. 2021, 22, bbaa343. [Google Scholar] [CrossRef]
- Hassanmoghadam, F.; Shokohi, T.; Hedayati, M.T.; Aslani, N.; Haghani, I.; Nabili, M.; Lotfali, E.; Davari, A.; Moazeni, M. High prevalence of itraconazole resistance among Candida parapsilosis isolated from Iran. Curr. Med. Mycol. 2019, 5, 43. [Google Scholar] [CrossRef]
- Galia, L.; Pezzani, M.D.; Compri, M.; Callegari, A.; Rajendran, N.B.; Carrara, E.; Tacconelli, E.; Network, C.M.E.-N. Surveillance of Antifungal Resistance in Candidemia Fails to Inform Antifungal Stewardship in European Countries. J. Fungi 2022, 8, 249. [Google Scholar] [CrossRef]
- Berkow, E.L.; Lockhart, S.R. Fluconazole resistance in Candida species: A current perspective. Infect. Drug Resist. 2017, 10, 237. [Google Scholar] [CrossRef]
- Whaley, S.G.; Berkow, E.L.; Rybak, J.M.; Nishimoto, A.T.; Barker, K.S.; Rogers, P.D. Azole antifungal resistance in Candida albicans and emerging non-albicans Candida species. Front. Microbiol. 2017, 7, 2173. [Google Scholar] [CrossRef]
- Ham, Y.Y.; Lewis, J.S.; Thompson III, G.R. Rezafungin: A novel antifungal for the treatment of invasive candidiasis. Future Microbiol. 2021, 16, 27–36. [Google Scholar] [CrossRef]
- Miesel, L.; Lin, K.Y.; Ong, V. Rezafungin treatment in mouse models of invasive candidiasis and aspergillosis: Insights on the PK/PD pharmacometrics of rezafungin efficacy. Pharmacol. Res. Perspect. 2019, 7, e00546. [Google Scholar] [CrossRef]
- Miesel, L.; Cushion, M.T.; Ashbaugh, A.; Lopez, S.R.; Ong, V. Efficacy of rezafungin in prophylactic mouse models of invasive candidiasis, aspergillosis, and pneumocystis pneumonia. Antimicrob. Agents Chemother. 2021, 65, e01992-20. [Google Scholar] [CrossRef]
- Lepak, A.J.; Zhao, M.; Andes, D.R. Determination of pharmacodynamic target exposures for rezafungin against Candida tropicalis and Candida dubliniensis in the neutropenic mouse disseminated candidiasis model. Antimicrob. Agents Chemother. 2019, 63, e01556-19. [Google Scholar] [CrossRef]
- Pfaller, M.A.; Carvalhaes, C.; Messer, S.A.; Rhomberg, P.R.; Castanheira, M. Activity of a long-acting echinocandin, rezafungin, and comparator antifungal agents tested against contemporary invasive fungal isolates (SENTRY Program, 2016 to 2018). Antimicrob. Agents Chemother. 2020, 64, e00099-20. [Google Scholar] [CrossRef]
- Farhadi, Z.; Farhadi, T.; Hashemian, S.M. Virtual screening for potential inhibitors of β (1, 3)-D-glucan synthase as drug candidates against fungal cell wall. J. Drug Assess. 2020, 9, 52–59. [Google Scholar] [CrossRef]
- Szymański, M.; Chmielewska, S.; Czyżewska, U.; Malinowska, M.; Tylicki, A. Echinocandins–structure, mechanism of action and use in antifungal therapy. J. Enzym. Inhib. Med. Chem. 2022, 37, 876–894. [Google Scholar] [CrossRef]
- Vallabhaneni, S.; Mody, R.K.; Walker, T.; Chiller, T. The global burden of fungal diseases. Infect. Dis Clin. 2016, 30, 1–11. [Google Scholar] [CrossRef]
- Alshaikh, N.A.; Perveen, K. Susceptibility of Fluconazole-Resistant Candida albicans to Thyme Essential Oil. Microorganisms 2021, 9, 2454. [Google Scholar] [CrossRef]
- Butassi, E.; Svetaz, L.; Carpinella, M.C.; Efferth, T.; Zacchino, S. Fungal biofilms as a valuable target for the discovery of natural products that cope with the resistance of medically important fungi—Latest findings. Antibiotics 2021, 10, 1053. [Google Scholar] [CrossRef]
- Stähli, A.; Schröter, H.; Bullitta, S.; Serralutzu, F.; Dore, A.; Nietzsche, S.; Milia, E.; Sculean, A.; Eick, S. In vitro activity of propolis on oral microorganisms and biofilms. Antibiotics 2021, 10, 1045. [Google Scholar] [CrossRef]
- Sokolonski, A.R.; Fonseca, M.S.; Machado, B.A.S.; Deegan, K.R.; Araújo, R.P.C.; Umsza-Guez, M.A.; Meyer, R.; Portela, R.W. Activity of antifungal drugs and Brazilian red and green propolis extracted with different methodologies against oral isolates of Candida spp. BMC Complement. Med. Ther. 2021, 21, 286. [Google Scholar] [CrossRef]
- Nani, B.D.; Sardi, J.d.C.O.; Lazarini, J.G.; Silva, D.R.; Massariolli, A.P.; Cunha, T.M.; de Alencar, S.M.; Franchin, M.; Rosalen, P.L. Anti-inflammatory and anti-Candida effects of Brazilian organic propolis, a promising source of bioactive molecules and functional food. J. Agric. Food Chem. 2019, 68, 2861–2871. [Google Scholar] [CrossRef]
- Tamfu, A.N.; Sawalda, M.; Fotsing, M.T.; Kouipou, R.M.T.; Talla, E.; Chi, G.F.; Epanda, J.J.E.; Mbafor, J.T.; Baig, T.A.; Jabeen, A. A new isoflavonol and other constituents from Cameroonian propolis and evaluation of their anti-inflammatory, antifungal and antioxidant potential. Saudi J. Biol. Sci. 2020, 27, 1659–1666. [Google Scholar] [CrossRef]
- Al-Ani, I.; Zimmermann, S.; Reichling, J.; Wink, M. Antimicrobial activities of European propolis collected from various geographic origins alone and in combination with antibiotics. Medicines 2018, 5, 2. [Google Scholar] [CrossRef]
- Okińczyc, P.; Paluch, E.; Franiczek, R.; Widelski, J.; Wojtanowski, K.K.; Mroczek, T.; Krzyżanowska, B.; Skalicka-Woźniak, K.; Sroka, Z. Antimicrobial activity of Apis mellifera L. and Trigona sp. propolis from Nepal and its phytochemical analysis. Biomed. Pharmacother. 2020, 129, 110435. [Google Scholar] [CrossRef]
- Freires, I.A.; Queiroz, V.C.P.P.; Furletti, V.F.; Ikegaki, M.; de Alencar, S.M.; Duarte, M.C.T.; Rosalen, P.L. Chemical composition and antifungal potential of Brazilian propolis against Candida spp. J. Mycol. Med. 2016, 26, 122–132. [Google Scholar] [CrossRef]
- Ikeda, N.Y.; Ambrosio, C.M.; Miano, A.C.; Rosalen, P.L.; Gloria, E.M.; Alencar, S.M. Essential oils extracted from organic propolis residues: An exploratory analysis of their antibacterial and antioxidant properties and volatile profile. Molecules 2021, 26, 4694. [Google Scholar] [CrossRef]
- Boisard, S.; Le Ray, A.-M.; Landreau, A.; Kempf, M.; Cassisa, V.; Flurin, C.; Richomme, P. Antifungal and antibacterial metabolites from a French poplar type propolis. Evid.-Based Complement. Altern. Med. 2015, 2015, 10. [Google Scholar] [CrossRef]
- Gucwa, K.; Kusznierewicz, B.; Milewski, S.; Van Dijck, P.; Szweda, P. Antifungal activity and synergism with azoles of polish propolis. Pathogens 2018, 7, 56. [Google Scholar] [CrossRef]
- Szweda, P.; Gucwa, K.; Kurzyk, E.; Romanowska, E.; Dzierżanowska-Fangrat, K.; Zielińska Jurek, A.; Kuś, P.M.; Milewski, S. Essential oils, silver nanoparticles and propolis as alternative agents against fluconazole resistant Candida albicans, Candida glabrata and Candida krusei clinical isolates. Indian J. Microbiol. 2015, 55, 175–183. [Google Scholar] [CrossRef]
- Martins, M.-L.; Cavalcanti, Y.-W. Red propolis hydroalcoholic extract inhibits the formation of Candida albicans biofilms on denture surface. J. Clin. Exp. Dent. 2020, 12, e626. [Google Scholar]
- Sayyadi, F.; Mahdavi, S.; Moghadamnia, A.A.; Moslemi, D.; Shirzad, A.; Motallebnejad, M. The effect of aqueous and ethanolic extract of Iranian propolis on Candida Albicans isolated from the mouth of patients with colorectal malignancy undergone chemotherapy: An in-vitro study. Caspian J. Intern. Med. 2020, 11, 62. [Google Scholar] [PubMed]
- Gavanji, S.; Larki, B. Comparative effect of propolis of honey bee and some herbal extracts on Candida albicans. Chin. J. Integr. Med. 2017, 23, 201–207. [Google Scholar] [CrossRef] [PubMed]
- Salamanca-Grosso, G.; Osorio-Tangarife, M.-P.; Cabrera-Moncayo, J.A. Propóleos de Nariño: Propiedades fisicoquímicas y actividad biológica. Biotecnol. Sect. Agropecu. Agroind. 2022, 20, 152–164. [Google Scholar] [CrossRef]
- Piccinelli, A.L.; Campo Fernandez, M.; Cuesta-Rubio, O.; Márquez Hernández, I.; De Simone, F.; Rastrelli, L. Isoflavonoids isolated from Cuban propolis. J. Agric. Food Chem. 2005, 53, 9010–9016. [Google Scholar] [CrossRef]
- Wolniak, M.; Oszmiański, J.; Wawer, I. Solid-state NMR studies and DFT calculations of flavonoids: Baicalein, baicalin and wogonoside. Magn. Reson. Chem. 2008, 46, 215–225. [Google Scholar] [CrossRef]
- Han, M.-S.; Lee, I.-K.; Kim, Y.-S.; Kim, J.T.; Choe, K.-R.; Yun, B.-S. Flavonoids from propolis inhibit DNA single strand breakage by the fenton reaction. J. Korean Soc. Appl. Biol. Chem. 2010, 53, 512–515. [Google Scholar] [CrossRef]
- Greenaway, W.; Scaysbrook, T.; Whatley, F.R. The analysis of bud exudate of Populus x euramericana, and of propolis, by gas chromatography–mass spectrometry. Proc. R. Soc. Lond. Ser. B. Biol. Sci. 1987, 232, 249–272. [Google Scholar]
- Su, Y.-L. High-Performance Liquid Chromatography-Mass Spectrometry for the Determination of Flavonoids in G. biloba Leaves. Food Sci. Technol Res. 2016, 22, 199–204. [Google Scholar] [CrossRef]
- Fathoni, A.; Saepudin, E.; Cahyana, A.H.; Rahayu, D.; Haib, J. Identification of nonvolatile compounds in clove (Syzygium aromaticum) from Manado. In Proceedings of the AIP Conference Proceedings, Depok, Indonesia, 1–2 November 2016; p. 030079. [Google Scholar]
- Olennikov, D.; Chirikova, N. Rhamnetin glycosides from the genus Spiraea. Chem. Nat. Compd. 2018, 54, 41–45. [Google Scholar] [CrossRef]
- Amedei, A.; M. D’Elios, M. New therapeutic approaches by using microorganism-derived compounds. Curr. Med. Chem. 2012, 19, 3822–3840. [Google Scholar] [CrossRef] [PubMed]
- Habbu, P.; Warad, V.; Shastri, R.; Madagundi, S.; Kulkarni, V.H. Antimicrobial metabolites from marine microorganisms. Chin. J. Nat. Med. 2016, 14, 101–116. [Google Scholar] [CrossRef]
- Toreti, V.C.; Sato, H.H.; Pastore, G.M.; Park, Y.K. Recent progress of propolis for its biological and chemical compositions and its botanical origin. Evid.-Based Complement. Altern. Med. 2013, 2013, 13. [Google Scholar] [CrossRef] [PubMed]
- Ruiz-Hurtado, P.A.; Garduño-Siciliano, L.; Dominguez-Verano, P.; Martinez-Galero, E.; Canales-Martinez, M.M.; Rodriguez-Monroy, M.A. Evaluation of the gastroprotective effects of Chihuahua propolis on indomethacin-induced gastric ulcers in mouse. Biomed. Pharmacother. 2021, 137, 111345. [Google Scholar] [CrossRef]
- Cui, J.; Duan, X.; Ke, L.; Pan, X.; Liu, J.; Song, X.; Ma, W.; Zhang, W.; Liu, Y.; Fan, Y. Extraction, purification, structural character and biological properties of propolis flavonoids: A review. Fitoterapia 2021, 157, 105106. [Google Scholar] [CrossRef]
- Rivera-Yañez, N.; Rodriguez-Canales, M.; Nieto-Yañez, O.; Jimenez-Estrada, M.; Ibarra-Barajas, M.; Canales-Martinez, M.; Rodriguez-Monroy, M. Hypoglycaemic and antioxidant effects of propolis of Chihuahua in a model of experimental diabetes. Evid.-Based Complementary Altern. Med. 2018, 2018, 10. [Google Scholar] [CrossRef]
- Haghdoost, N.; Salehi, T.; Khosravi, A.; Sharifzadeh, A. Antifungal activity and influence of propolis against germ tube formation as a critical virulence attribute by clinical isolates of Candida albicans. J. De Mycol. Med. 2016, 26, 298–305. [Google Scholar] [CrossRef]
- Granados Pineda, J.; Pérez Rojas, J.M. Advances in Chemical Composition and Biological Activity of Mexican Propolis. LOJ Pharmacol. Clin. Res. 2020, 2, 194–201. [Google Scholar] [CrossRef]
- Santos, L.M.; Fonseca, M.S.; Sokolonski, A.R.; Deegan, K.R.; Araújo, R.P.; Umsza-Guez, M.A.; Barbosa, J.D.; Portela, R.D.; Machado, B.A. Propolis: Types, composition, biological activities, and veterinary product patent prospecting. J. Sci. Food Agric. 2020, 100, 1369–1382. [Google Scholar] [CrossRef]
- Ristivojević, P.; Trifković, J.; Andrić, F.; Milojković-Opsenica, D. Poplar-type propolis: Chemical composition, botanical origin and biological activity. Nat. Prod. Commun. 2015, 10, 1869–1876. [Google Scholar] [CrossRef]
- Salatino, A.; Fernandes-Silva, C.C.; Righi, A.A.; Salatino, M.L.F. Propolis research and the chemistry of plant products. Nat. Prod. Rep. 2011, 28, 925–936. [Google Scholar] [CrossRef]
- Lombardi, A.; Ouanounou, A. Fungal infections in dentistry: Clinical presentations, diagnosis, and treatment alternatives. Oral Surg. Oral Med. Oral Pathol. Oral Radiol. 2020, 130, 533–546. [Google Scholar] [CrossRef]
- Matsumoto, H.; Nagao, J.-i.; Cho, T.; Kodama, J. Evaluation of pathogenicity of Candida albicans in germination-ready states using a silkworm infection model. Med. Mycol. J. 2013, 54, 131–140. [Google Scholar] [CrossRef]
- Mayer, K.; Patula, S.; Krapp, M.; Leppig, B.T.; Poschinger, A. Danger map for the Bavarian Alps. Z. Dtsch. Ges. Geowiss. 2010, 119–128. [Google Scholar] [CrossRef]
- Nailis, H.; Kucharíková, S.; Řičicová, M.; Van Dijck, P.; Deforce, D.; Nelis, H.; Coenye, T. Real-time PCR expression profiling of genes encoding potential virulence factors in Candida albicans biofilms: Identification of model-dependent and-independent gene expression. BMC Microbiol. 2010, 10, 114. [Google Scholar] [CrossRef]
- Villar, C.; Kashleva, H.; Dongari-Bagtzoglou, A. Role of Candida albicans polymorphism in interactions with oral epithelial cells. Oral Microbiol. Immunol. 2004, 19, 262–269. [Google Scholar] [CrossRef]
- Gomaa, O.M.; Gaweesh, A.S. Variation in adhesion and germ tube formation of oral Candida using Egyptian propolis. Can. J. Microbiol. 2013, 59, 197–203. [Google Scholar] [CrossRef] [PubMed]
- Khan, M.S.; Ahmad, I.; Cameotra, S.S.; Botha, F. Sub-MICs of Carum copticum and Thymus vulgaris influence virulence factors and biofilm formation in Candida spp. BMC Complementary Altern. Med. 2014, 14, 337. [Google Scholar] [CrossRef]
- Quintero-Mora, M.L.; Londoño-Orozco, A.; Hernández-Hernández, F.; Manzano-Gayosso, P.; López-Martínez, R.; Soto-Zárate, C.I.; Carrillo-Miranda, L.; Penieres-Carrillo, G.; García-Tovar, C.G.; Cruz-Sánchez, T.A. Efecto de extractos de propóleos mexicanos de Apis mellifera sobre el crecimiento in vitro de Candida albicans. Rev. Iberoam. Micol. 2008, 25, 22–26. [Google Scholar] [CrossRef]
- Neto, M.R.; Tintino, S.R.; da Silva, A.R.P.; do Socorro Costa, M.; Boligon, A.A.; Matias, E.F.; de Queiroz Balbino, V.; Menezes, I.R.; Coutinho, H.D.M. Seasonal variation of Brazilian red propolis: Antibacterial activity, synergistic effect and phytochemical screening. Food Chem. Toxicol. 2017, 107, 572–580. [Google Scholar]
- Sforcin, J.; Fernandes, A., Jr.; Lopes, C.; Bankova, V.; Funari, S. Seasonal effect on Brazilian propolis antibacterial activity. J. Ethnopharmacol. 2000, 73, 243–249. [Google Scholar] [CrossRef]
- Kosalec, I.; Pepeljnjak, S.; Bakmaz, M.; Vladimir-Knežević, S. Flavonoid analysis and antimicrobial activity of commercially available propolis products. Acta Pharm. 2005, 55, 423–430. [Google Scholar] [PubMed]
- Bankova, V.; Popova, M.; Bogdanov, S.; Sabatini, A.-G. Chemical composition of European propolis: Expected and unexpected results. Z. Nat. C 2002, 57, 530–533. [Google Scholar] [CrossRef] [PubMed]
- Kujumgiev, A.; Tsvetkova, I.; Serkedjieva, Y.; Bankova, V.; Christov, R.; Popov, S. Antibacterial, antifungal and antiviral activity of propolis of different geographic origin. J. Ethnopharmacol. 1999, 64, 235–240. [Google Scholar] [CrossRef]
- D’auria, F.; Tecca, M.; Scazzocchio, F.; Renzini, V.; Strippoli, V. Effect of propolis on virulence factors of Candida albicans. J. Chemother. 2003, 15, 454–460. [Google Scholar] [CrossRef]
- Zarnowski, R.; Westler, W.M.; Lacmbouh, G.A.; Marita, J.M.; Bothe, J.R.; Bernhardt, J.; Lounes-Hadj Sahraoui, A.; Fontaine, J.; Sanchez, H.; Hatfield, R.D. Novel entries in a fungal biofilm matrix encyclopedia. MBio 2014, 5, e01333-14. [Google Scholar] [CrossRef]
- Bankova, V. Chemical diversity of propolis and the problem of standardization. J. Ethnopharmacol. 2005, 100, 114–117. [Google Scholar] [CrossRef]
- López, A.; Ming, D.S.; Towers, G.N. Antifungal Activity of Benzoic Acid Derivatives from Piper l anceaefolium. J. Nat. Prod. 2002, 65, 62–64. [Google Scholar] [CrossRef]
- Hegazi, A.G.; Abd El Hady, F.K.; Abd Allah, F.A. Chemical composition and antimicrobial activity of European propolis. Z. Nat. C 2000, 55, 70–75. [Google Scholar] [CrossRef]
- Metzner, J.; Schneidewind, E. Effect of pinocembrin on the course of experimental Candida infections in mice. Mykosen 1978, 21, 257–262. [Google Scholar] [CrossRef]
- Kanchanapiboon, J.; Kongsa, U.; Pattamadilok, D.; Kamponchaidet, S.; Wachisunthon, D.; Poonsatha, S.; Tuntoaw, S. Boesenbergia rotunda extract inhibits Candida albicans biofilm formation by pinostrobin and pinocembrin. J. Ethnopharmacol. 2020, 261, 113193. [Google Scholar] [CrossRef]
- Singh, B.; A. Sharma, R. Anti-inflammatory and antimicrobial properties of flavonoids from Heliotropium subulatum exudate. Inflamm. Allergy-Drug Targets (Former. Curr. Drug Targets-Inflamm. Allergy) (Discontin.) 2015, 14, 125–132. [Google Scholar] [CrossRef]
- Bujdáková, H.; Didiášová, M.; Drahovská, H.; Černáková, L. Role of cell surface hydrophobicity in Candida albicans biofilm. Open Life Sci. 2013, 8, 259–262. [Google Scholar] [CrossRef]
- Zhao, X.; Daniels, K.J.; Oh, S.-H.; Green, C.B.; Yeater, K.M.; Soll, D.R.; Hoyer, L.L. Candida albicans Als3p is required for wild-type biofilm formation on silicone elastomer surfaces. Microbiology 2006, 152, 2287. [Google Scholar] [CrossRef]
- Phan, Q.T.; Myers, C.L.; Fu, Y.; Sheppard, D.C.; Yeaman, M.R.; Welch, W.H.; Ibrahim, A.S.; Edwards, J.E., Jr.; Filler, S.G. Als3 is a Candida albicans invasin that binds to cadherins and induces endocytosis by host cells. PLoS Biol. 2007, 5, e64. [Google Scholar] [CrossRef]
- Zou, H.; Fang, H.M.; Zhu, Y.; Wang, Y. Candida albicans Cyr1, Cap1 and G-actin form a sensor/effector apparatus for activating cAMP synthesis in hyphal growth. Mol. Microbiol. 2010, 75, 579–591. [Google Scholar] [CrossRef]
- Nailis, H.; Coenye, T.; Van Nieuwerburgh, F.; Deforce, D.; Nelis, H.J. Development and evaluation of different normalization strategies for gene expression studies in Candida albicans biofilms by real-time PCR. BMC Mol. Biol. 2006, 7, 25. [Google Scholar] [CrossRef]
- Manoharan, R.K.; Lee, J.-H.; Kim, Y.-G.; Lee, J. Alizarin and chrysazin inhibit biofilm and hyphal formation by Candida albicans. Front. Cell. Infect. Microbiol. 2017, 7, 447. [Google Scholar] [CrossRef]
- Kim, H.; Lee, D.G. Naringin-generated ROS promotes mitochondria-mediated apoptosis in Candida albicans. IUBMB Life 2021, 73, 953–967. [Google Scholar] [CrossRef]
- Andrade-Pavón, D.; Gómez-García, O.; Villa-Tanaca, L. Molecular recognition of citroflavonoids naringin and naringenin at the active site of the HMG-CoA reductase and DNA topoisomerase type ii enzymes of Candida spp. and Ustilago maydis. Indian J. Microbiol. 2022, 62, 79–87. [Google Scholar] [CrossRef]
- Scotti, L.; Bezerra Mendonca, F.J.; Ribeiro, F.F.; Tavares, J.F.; da Silva, M.S.; Barbosa Filho, J.M.; Scotti, M.T. Natural product inhibitors of topoisomerases: Review and docking study. Curr. Protein Pept. Sci. 2018, 19, 275–291. [Google Scholar] [CrossRef] [PubMed]
- Singh, S.; Pandey, V.P.; Yadav, K.; Yadav, A.; Dwivedi, U. Natural products as anti-cancerous therapeutic molecules targeted towards topoisomerases. Curr. Protein Pept. Sci. 2020, 21, 1103–1142. [Google Scholar] [CrossRef] [PubMed]
- Hernández-Cánovas, J.d.D.; Guillén-López, I.; Vizcaíno-Milla, P.; Andreo-López, M.; Sánchez-Rubio, M.; Taboada-Rodríguez, A.; Marín-Iniesta, F. Antimicrobial activity of Citrus spp. and Anethum graveolens components against Candida metapsilosis in ranch sauce. J. Food Sci. Technol. 2020, 57, 2713–2721. [Google Scholar] [CrossRef] [PubMed]
- Ertaş, A.; Boǧa, M.; Yılmaz, M.A.; Yeşil, Y.; Haşimi, N.; Kaya, M.S.e.; Temel, H.; Kolak, U. Chemical compositions by using LC-MS/MS and GC-MS and biological activities of Sedum sediforme (Jacq.) Pau. J. Agric. Food Chem. 2014, 62, 4601–4609. [Google Scholar] [CrossRef]
- Rashed, K.N.; Butnariu, M. Isolation and antimicrobial and antioxidant evaluation of bio-active compounds from Eriobotrya japonica stems. Adv. Pharm. Bull. 2014, 4, 75. [Google Scholar]
- Shirley, K.P.; Windsor, L.J.; Eckert, G.J.; Gregory, R.L. In vitro effects of Plantago major extract, aucubin, and baicalein on Candida albicans biofilm formation, metabolic activity, and cell surface hydrophobicity. J. Prosthodont. 2017, 26, 508–515. [Google Scholar] [CrossRef]
- Cao, Y.; Dai, B.; Wang, Y.; Huang, S.; Xu, Y.; Cao, Y.; Gao, P.; Zhu, Z.; Jiang, Y. In vitro activity of baicalein against Candida albicans biofilms. Int. J. Antimicrob. Agents 2008, 32, 73–77. [Google Scholar] [CrossRef]
- Yu, J.S.; Park, M.; Pang, C.; Rashan, L.; Jung, W.H.; Kim, K.H. Antifungal phenols from Woodfordia uniflora collected in Oman. J. Nat. Prod. 2020, 83, 2261–2268. [Google Scholar] [CrossRef]
- Rocha, M.F.G.; Sales, J.A.; da Rocha, M.G.; Galdino, L.M.; de Aguiar, L.; Pereira-Neto, W.d.A.; de Aguiar Cordeiro, R.; Castelo-Branco, D.d.S.C.M.; Sidrim, J.J.C.; Brilhante, R.S.N. Antifungal effects of the flavonoids kaempferol and quercetin: A possible alternative for the control of fungal biofilms. Biofouling 2019, 35, 320–328. [Google Scholar] [CrossRef]
- Shao, J.; Zhang, M.; Wang, T.; Li, Y.; Wang, C. The roles of CDR1, CDR2, and MDR1 in kaempferol-induced suppression with fluconazole-resistant Candida albicans. Pharm. Biol. 2016, 54, 984–992. [Google Scholar] [CrossRef]
- Da Silva, C.R.; de Andrade Neto, J.B.; de Sousa Campos, R.; Figueiredo, N.S.; Sampaio, L.S.; Magalhães, H.I.F.; Cavalcanti, B.C.; Gaspar, D.M.; de Andrade, G.M.; Lima, I.S.P. Synergistic effect of the flavonoid catechin, quercetin, or epigallocatechin gallate with fluconazole induces apoptosis in Candida tropicalis resistant to fluconazole. Antimicrob. Agents Chemother. 2014, 58, 1468–1478. [Google Scholar] [CrossRef]
- Rajasekharan, S.K.; Ramesh, S.; Bakkiyaraj, D. Synergy of flavonoids with HDAC inhibitor: New approach to target Candida tropicalis biofilms. J. Chemother. 2015, 27, 246–249. [Google Scholar] [CrossRef]
- Niimi, M.; Niimi, K.; Takano, Y.; Holmes, A.R.; Fischer, F.J.; Uehara, Y.; Cannon, R.D. Regulated overexpression of CDR1 in Candida albicans confers multidrug resistance. J. Antimicrob. Chemother. 2004, 54, 999–1006. [Google Scholar] [CrossRef] [PubMed][Green Version]
- Holmes, A.R.; Keniya, M.V.; Ivnitski-Steele, I.; Monk, B.C.; Lamping, E.; Sklar, L.A.; Cannon, R.D. The monoamine oxidase A inhibitor clorgyline is a broad-spectrum inhibitor of fungal ABC and MFS transporter efflux pump activities which reverses the azole resistance of Candida albicans and Candida glabrata clinical isolates. Antimicrob. Agents Chemother. 2012, 56, 1508–1515. [Google Scholar] [CrossRef]
- Prasad, R.; Rawal, M.K. Efflux pump proteins in antifungal resistance. Front. Pharmacol. 2014, 5, 202. [Google Scholar] [CrossRef]
- Borges-Walmsley, M.I.; Walmsley, A.R. cAMP signalling in pathogenic fungi: Control of dimorphic switching and pathogenicity. Trends Microbiol. 2000, 8, 133–141. [Google Scholar] [CrossRef]
- Saito, H.; Tamura, M.; Imai, K.; Ishigami, T.; Ochiai, K. Catechin inhibits Candida albicans dimorphism by disrupting Cek1 phosphorylation and cAMP synthesis. Microb. Pathog. 2013, 56, 16–20. [Google Scholar] [CrossRef]
- Ning, Y.; Ling, J.; Wu, C.D. Synergistic effects of tea catechin epigallocatechin gallate and antimycotics against oral Candida species. Arch. Oral Biol. 2015, 60, 1565–1570. [Google Scholar] [CrossRef]
- Popova, M.; Gerginova, D.; Trusheva, B.; Simova, S.; Tamfu, A.N.; Ceylan, O.; Clark, K.; Bankova, V. A preliminary study of chemical profiles of honey, cerumen, and propolis of the African stingless bee Meliponula ferruginea. Foods 2021, 10, 997. [Google Scholar] [CrossRef]
- Tamfu, A.N.; Ceylan, O.; Cârâc, G.; Talla, E.; Dinica, R.M. Antibiofilm and Anti-Quorum Sensing Potential of Cycloartane-Type Triterpene Acids from Cameroonian Grassland Propolis: Phenolic Profile and Antioxidant Activity of Crude Extract. Molecules 2022, 27, 4872. [Google Scholar] [CrossRef]
- Cushnie, T.T.; Lamb, A.J. Recent advances in understanding the antibacterial properties of flavonoids. Int. J. Antimicrob. Agents 2011, 38, 99–107. [Google Scholar] [CrossRef] [PubMed]
- Gabriela, N.; Rosa, A.M.; Catiana, Z.I.; Soledad, C.; Mabel, O.R.; Esteban, S.J.; Veronica, B.; Daniel, W.; Ines, I.M. The effect of Zuccagnia punctata, an argentine medicinal plant, on virulence factors from Candida species. Nat. Prod. Commun. 2014, 9, 933–936. [Google Scholar] [CrossRef] [PubMed]
- CLSI. Method for Antifungal Disk Diffusion Susceptibility Testing of Yeasts, 3rd ed.; CLSI guideline M44; Clinical and Laboratory Standards Institute: Wayne, PA, USA, 2018; Available online: https://clsi.org/standards/products/microbiology/documents/m44/ (accessed on 29 August 2022).
- CLSI. Reference Method for Broth Dilution Antifungal Susceptibility Testing of Yeast, 4th ed.; CLSI standard M27; Clinical and Laboratory Standards Institute: Wayne, PA, USA, 2017; Available online: https://clsi.org/standards/products/microbiology/documents/m27/ (accessed on 29 August 2022).
- Rivera-Yañez, C.R.; Terrazas, L.I.; Jimenez-Estrada, M.; Campos, J.E.; Flores-Ortiz, C.M.; Hernandez, L.B.; Cruz-Sanchez, T.; Garrido-Fariña, G.I.; Rodriguez-Monroy, M.A.; Canales-Martinez, M.M. Anti-Candida activity of Bursera morelensis Ramirez essential oil and two compounds, α-pinene and γ-terpinene—An in vitro study. Molecules 2017, 22, 2095. [Google Scholar] [CrossRef]

| Candida Strain | Sample | Propolis (mm) | Nystatin (mm) |
|---|---|---|---|
| C. krusei | CC1 | 8.83 ± 0.11 | 9.7 ± 0.58 |
| CC5 | 7.60 ± 0.10 | 18.0 ± 0.98 | |
| CC9 | 8.82 ± 0.11 f | 19.5 ± 0.87 f | |
| C. albicans | CC2 | 9.80 ± 0.26 | 19.0 ± 1.00 |
| CC3 | 9.50 ± 0.34 | 20.1 ± 1.00 | |
| CC4 | 8.83 ± 0.28 | 18.7 ± 1.15 | |
| CC7 | 9.80 ± 0.10 f | 19.5 ± 0.45 f | |
| CC8 | 9.56 ± 0.55 f | 18.4 ± 1.21 f | |
| CC10 | 10 ± 1 f | 21.3 ± 1.01 f | |
| C. glabrata | CC6 | 21.43 ± 1.30 a, b, c, d, e | 36.7 ± 1.88 a, b, c, d, e |
| Candida Strain | Sample | Propolis | Nystatin | ||||
|---|---|---|---|---|---|---|---|
| MFC | FC75 | FC50 | MFC | FC75 | FC50 | ||
| C. krusei | CC1 | 625 * | 195 ± 0.0135 | 107 ± 0.0075 | 5 | 3.79 ± 0.0012 | 2.56 ± 0.0015 |
| CC5 | 1250 * | 331 ± 0.0150 | 244 ± 0.0080 | 10 | 6.70 ± 0.0023 | 4.11 ± 0.0015 | |
| CC9 | 625 * | 234 ± 0.0185 | 109 ± 0.0110 | 5 | 3.33 ± 0.0017 | 2.05 ± 0.0012 | |
| C. albicans | CC2 | 312 * | 98 ± 0.0215 | 59 ± 0.0142 | 2 | 1.81 ± 0.0010 | 1.19 ± 0.0012 |
| CC3 | 312 * | 75 ± 0.0165 | 48 ± 0.0090 | 2 | 1.63 ± 0.0006 | 1 ± 0.0015 | |
| CC4 | 1250 * | 492 ± 0.0220 | 237 ± 0.0195 | 10 | 7.37 ± 0.0020 | 4.85 ± 0.017 | |
| CC7 | 1250 * | 19 ± 0.0067 | 14 ± 0.0031 | 10 | 5.51 ± 0.0021 | 3.14 ± 0.0020 | |
| CC8 | 625 * | 28 ± 0.0045 | 18 ± 0.0020 | 5 | 2.69 ± 0.0023 | 1.54 ± 0.0021 | |
| CC10 | 1250 * | 21 ± 0.0030 | 15 ± 0.0015 | 10 | 6.55 ± 0.0025 | 3.96 ± 0.0017 | |
| C. glabrata | CC6 | 312 * | 59 ± 0.0131 | 30 ± 0.0055 | 2 | 1.53 ± 0.0020 | 0.92 ± 0.0010 |
| C. albicans. | IC50 |
|---|---|
| CC2 | 108 ± 0.0021 |
| CC3 | 138 ± 0.0012 |
| CC4 | 1291 ± 0.0141 |
| CC7 | 33 ± 0.0006 |
| CC8 | 30 ± 0.0010 |
| CC10 | 19 ± 0.0015 |
Publisher’s Note: MDPI stays neutral with regard to jurisdictional claims in published maps and institutional affiliations. |
© 2022 by the authors. Licensee MDPI, Basel, Switzerland. This article is an open access article distributed under the terms and conditions of the Creative Commons Attribution (CC BY) license (https://creativecommons.org/licenses/by/4.0/).
Share and Cite
Rivera-Yañez, C.R.; Ruiz-Hurtado, P.A.; Reyes-Reali, J.; Mendoza-Ramos, M.I.; Vargas-Díaz, M.E.; Hernández-Sánchez, K.M.; Pozo-Molina, G.; Méndez-Catalá, C.F.; García-Romo, G.S.; Pedroza-González, A.; et al. Antifungal Activity of Mexican Propolis on Clinical Isolates of Candida Species. Molecules 2022, 27, 5651. https://doi.org/10.3390/molecules27175651
Rivera-Yañez CR, Ruiz-Hurtado PA, Reyes-Reali J, Mendoza-Ramos MI, Vargas-Díaz ME, Hernández-Sánchez KM, Pozo-Molina G, Méndez-Catalá CF, García-Romo GS, Pedroza-González A, et al. Antifungal Activity of Mexican Propolis on Clinical Isolates of Candida Species. Molecules. 2022; 27(17):5651. https://doi.org/10.3390/molecules27175651
Chicago/Turabian StyleRivera-Yañez, Claudia Rebeca, Porfirio Alonso Ruiz-Hurtado, Julia Reyes-Reali, María Isabel Mendoza-Ramos, María Elena Vargas-Díaz, Karla Mariela Hernández-Sánchez, Glustein Pozo-Molina, Claudia Fabiola Méndez-Catalá, Gina Stella García-Romo, Alexander Pedroza-González, and et al. 2022. "Antifungal Activity of Mexican Propolis on Clinical Isolates of Candida Species" Molecules 27, no. 17: 5651. https://doi.org/10.3390/molecules27175651
APA StyleRivera-Yañez, C. R., Ruiz-Hurtado, P. A., Reyes-Reali, J., Mendoza-Ramos, M. I., Vargas-Díaz, M. E., Hernández-Sánchez, K. M., Pozo-Molina, G., Méndez-Catalá, C. F., García-Romo, G. S., Pedroza-González, A., Méndez-Cruz, A. R., Nieto-Yañez, O., & Rivera-Yañez, N. (2022). Antifungal Activity of Mexican Propolis on Clinical Isolates of Candida Species. Molecules, 27(17), 5651. https://doi.org/10.3390/molecules27175651

